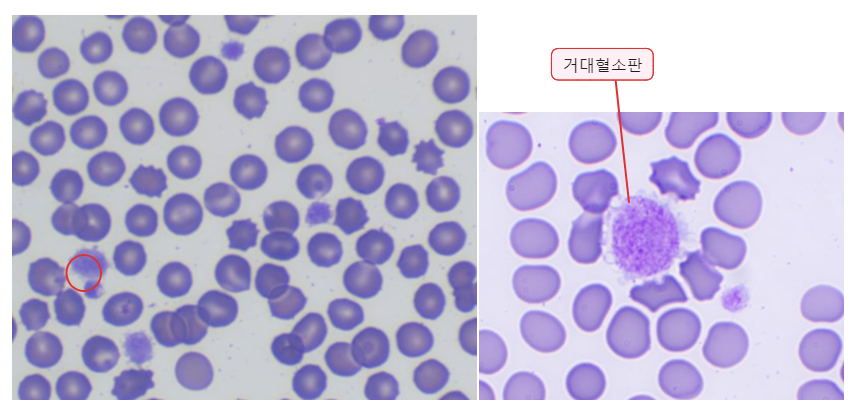

Common Immune-Mediated Disease 4) Immune-Mediated Thrombocytopenia
1. Classification/Etiology
- ITP = idiopathic thrombocytopenic purpura
- IMT = Immune-mediated thrombocytopenia 라고도 함.
- 혈소판이 감소하여 멍이 잘 듦.
- 항체매개로 가속화된 혈소판의 감소가 유발한 thrombocytopenia (accelerated destruction of platelets)
- 개에서 심각한 thrombocytopenia? ITP 때문일 때가 가장 흔하다.
Primary autoimmune thrombocytopenia
- Antibodies - platelet antigens의 결합
- Platelet membrane glycoproteins Ⅱb/Ⅲa + Others
- 주로 면역 조절의 결함으로 인해 발생한다.
- 개에서는 흔한 원인이나, 고양이에서는 드물다.
- stress, 환경 온도의 변화, 호르몬 변화, 백신의 이물, 수술 등 환경적 요인으로 나타날 수 있다.
임병 - 혈소판의 특징
Ⅰ. 혈소판의 특징
- Platelet(혈소판, thrombocytes) : Megakaryocytes의 작은 세포질 조각.
- Hematopoiesis 중 Thrombopoiesis를 통해 생성됨.
Link to original
Resting platelet : 정상적으로 채혈했을 때 말초 혈액에서 관찰되는 모양이다.
Activated platelet : 출혈 등 혈소판의 작용이 필요한 상황이 발생했을 때, 형태가 변화되고 platelet aggregation이 발생하여 clot을 형성한다.
Peripheral zone : coagulation과 관련된 부분으로, phospholipid membrane에 glycoprotein으로 cell-cell interaction을 한다.
Open canalicular system (OCS) : 모양을 바꾸면서 membrane이 안쪽으로 함입하도록 돕느다.
- Activated platelet에서 위족(pseudopod)을 가진 모양처럼 변함.
- Platelet과 plasma가 반응하고 접착하는 데 중요 - OCS를 통해 탈과립되어 plasma로 노출됨.
Cytoskeleton system (Sol-Gel zone)
- Resting의 discoid shape을 유지하는 데 중요한 역할.
- Activated platelet의 위족(pseudopod) 형성에 기여함.
- Microtubular ring, actin, myosin이 많이 포함됨.
Organelle zone : dense tubular system으로, 세포질 내부에 혈소판의 생리적 활성에 필요한 물질을 저장한다.
- α-granules : 지혈이나 혈관 치유에 관여하는 PDGF(Platelet-Derived Growth Factor), PF4(Platelet Factor 4), Thrombospondin 등을 포함한다.
- Dense granules : Ca2+, Mg2+, ADT, ATP, Serotonin 등으로 포함한다.
PDGF growth factor 저장
Secondary ITP
- 기저질환(inflammatory or neoplastic disease)에 의해 → 항체 매개 혈소판 파괴가 나타남.
- Evans syndrome : ITP + IMHA
- SLE
Table. Secondary ITP의 원인
| Cause | Dogs | Cats |
|---|---|---|
| Neoplasia | Lymphoma Hemangiosarcoma Leukemia Malignant histiocytosis Histiocytic sarcoma Unclassified carcinoma/sarcoma … | Lymphoma Hemangiosarcoma Leukemia … |
| Infection | Ehrlichia canis Anaplasma phagocytophilum Anaplasma platys Rocky Mountain spotted fever Babesiosis Leishmaniasis Leptospirosis Distemper virus infection … | Feline leukemia virus Feline immunodeficiency virus Feline infectious peritonitis virus Feline panleukopenia cirus Toxoplasmosis |
| Exposure to drugs, vaccines, toxins | 항생제 (Trimethoprim, sulfadiazine 등) Phenobarbital Primidone | Griseofulvin Methimazole Albendazole Chloramphenicol |
| DIC | Neoplasia Hepatic disease Infection Pancreatitis | Neoplasia Hepatic disease Infection Pancreatitis |
| Inherited macrothrombocytopenia | Cavalier King Charles Spaniel Norfolk Terrier Beagle |
논문 소개) 백신 접종과 ITP 발병은 관련 있을까?
- ITP 걸린 48마리 중 백신 맞은 건 8% 정도,,
- 별로 상관관계가 없는 것 같다?
2. Clinical Features
- 평균 6년령, but 광범위하게 발병 (8개월-15살)
- Female >> males (암컷에서 2배 정도 더 많이 발병)
- 어떤 품종에서도 걸릴 수 있으나,
- Cocker Spaniel, Poodles (all), German Shepherd, Old English Sheepdog
Common findings
- 초기 : 혈소판이 없어 자반이 생김 (피부와 점막에 Petechial & ecchymotic hemorrhages)
- 지혈이 잘 안 됨 → Epistaxis, Hematochezia(혈변), Hematemesis(혈토), Easy bruising(멍이 잘 듦)
- Lethargy, Weakness, Anorexia (증상이 지속되면 기력 빠짐)
신체검사 상 Additional findings -수의사의 주의
- Evidence of melena or hematochezia (잠혈 주의)
- Hematuria (보호자가 놓칠 수 있는 미세한 혈뇨 주의)
- Hyphema(전방출혈), Retinal hemorrhage → 안구 쪽 출혈로 blindness
- Pale MMC
- 뇌혈관 출혈로 인해 Neurologic signs (+눈 관련 증상)
- 혈소판 감소는 rapid하게 발생하나, 진행 속도는 느림. 빈혈과 같이 생명을 위협하는 소견은 천천히 나타남(life-threatening hemorrhage is rare)
- Cf) ITP 걸린 개의 혈청과 platelet과 incubation → 혈소판이 기능을 잃음. (응집 불가)
⇒ ITP 걸린 개의 혈청에 무언가 혈소판을 무력화시키는 항체나 다른 factor가 존재하는 것 같다 - 예외적으로, Evans syndrome의 경우 혈소판+적혈구가 한 번에 감소하기 때문에 심각할 수 있음.
- 혈소판을 충분히 넣어줬는데도 떨어진다면, 다른 원인이 있을 수도 있다
혈소판의 성숙 과정 : 성숙하면서 작아짐.
- Megakaryocyte의 꼬리 같은 부분이 떨어져 나오면서 혈소판이 됨.
- 품종 소인 - 일부 종에서 선천적으로 혈소판이 적거나, 큰 혈소판을 가진 경우 있음
- Greyhound : 혈소판 수치가 보통보다 낮은 편. (but 출혈 위험이 높아지는 건 X)
- 참고) 우리나라에서 보이는 그레이하운드는 보통 Italian이라 해당 X, Hgb 높고 Fe도 높음.
- Cavalier King Charles Spaniels, Norfolk Terrier : Macrothrombocytopenia
- β1-tubulin mutation으로 인해 → 혈소판 수 감소(<30,000/μL), MPV 증가
- 출혈 소견 없음, 치료 필요 없음 (그냥 품종 소인)
- Greyhound : 혈소판 수치가 보통보다 낮은 편. (but 출혈 위험이 높아지는 건 X)
3. Diagnosis
- ITP는 다른 질병과 같이 발생할 때가 많음.
- Primary ITP의 진단은 다른 thrombocytpenia 원인을 rule-out함으로써 가능함.
✅ 혈액 검사
-
Primary ITP → 혈소판감소가 심각함. (<50,000 platelets/μL)
- Platelet counts는 primary ITP < secondary ITP < 비면역원성 thrombocytopenia(출혈 등)
-
혈액 도말에서
- Microthrombocytosis (Platelet fragments)
- 면역 손상(immune injury) 혹은 대형 혈소판이 먼저 제거되어서 나타난다.
- insensitive (발견되지 않는다고 해서 아닌 건 아니지만), but specific (발견되면 ITP일 가능성이 더 높음)
- Large platelets
- 골수에서 혈소판 생성 기능은 정상이라는 지표일 수도 있는데,
- 골수의 손상으로 실수로 큰 혈소판을 만들 수 있음.
- 따라서 재생반응일 수도 있지만, 아닐 수도 있음.
- Microthrombocytosis (Platelet fragments)
-
MPV (Mean Platelet Volume) : large platelet이 많으면 MPV ↑ , microthrombocytes가 많으면 MPV ↓
- thrombocytopenia가 있을 때, primary ITP는 MPV가 낮은 편이라는 교재의 연구 결과.
- MPV가 더 클 수도 있다는 최근 연구 결과.
-
Thrombocytopenia는 있는데 그로 인한 증상(자반, 쉽게 멍듦, 빈혈 등)이 없다면
- 진짜 혈소판 감소인지 생각해봐라 (품종 소인은 없는지) : Breed-related thrombocytopenia
- 혈소판이 많이 몰려있으면 정확히 측정 X (10만 개 이하면 꼭 도말 확인해보기) : Platelet clumping, spurious thrombocytopenia
- 기계에 따라 낮게 나오는 측정 기계도 있음 (중국산) : Technical problems
✅ 골수 검사
- 혈소판 생산 감소 / 혈소판 소모 증가 / 혈소판 파괴 중 무엇에 해당하는지 감별하기에 가장 좋은 방법.
- 권장되는 상황 : Severe thrombocytopenia (<20,000/μL) / or 다른 hematologic abnormalities (cytopenias)의 증거가 있을 때
⇒ DDx : Myelophthisis, neoplasia, megakaryotic aplasia, aplastic anemia- Megakaryocytic aplasia로 인해 심각한 혈소판 감소를 나타내는 경우는 드물다.
- primary일 수도 있지만, Ehrlichia canis, Borrelia burgdorferi(라임병) 등 감염에 대해 secondary할 수도 있다.
- ITP(특발성)과 비슷하지만, 더 심각하고 약물 반응이 떨어져 예후가 불량하다.
- 출혈 우려로 시도하지 않는 건 X - 심각한 혈소판감소증에서도 국소적으로 잘 지혈해서 안전하게 시행될 수 있다.
- Megakaryocytic hyperplasia > Megakaryocytes 정상 >>> Megakaryocytes 감소; 예후 안 좋음
✅ Platelet-bound antibody
- 원내 검사는 어렵고, 검사 의뢰 필요.
- 우리나라에서는 불가능하고, 미국에서도 가까운 지역에서만 가능한 방법.
- Highly sensitive : 음성이면 ITP 아닐 것.
- 이전에 면역억제 치료를 했으면 음성 결과가 나올 수 있음.
- 양성 결과가 나와도 primary ITP에 대해 non-specific - 속발성 원인이 따로 있을 수 있다.
- neoplasia, inflammation, drug reactions, infectious casuse 등
진단 알고리즘
- History, Physical exmination
- MDB (CBC, chemistry, urinalysis) /
Coagulation status (Platelet, aPTT, PT, FDPs) /
Imaging (Mass, 자궁축농증)- Infectious disease titers (지리적 요인 고려) /
Bone marrow exam (심각한 경우)
- ITP의 대부분은 megakaryocytic hyperplasia
- 드물게 나타나는 megakaryocytic aplasia / hypoplasia ⇒ 골수검사로만 진단 가능. (루틴한 면역억제 치료에 반응하지 않을 때 뒤늦게 시행되기도 함)
Fig. ITP 진단 과정에 대한 최신 가이드라인
Treatment
- 면역억제제 치료가 핵심.
- 감염원 검사에 시간이 소요될 수 있으니, 결과를 기다려볼 것 / 그러나 배제되기 전 애매하면 doxycycline 그냥 같이 주기도 함.
1) Corticosteroid
| Corticosteroids | |
|---|---|
| PDS | 2-4mg/kg/day PO |
| Dexamethasone | 0.25-0.6mg/kg IV q24h - 1,2번 소량 투여 |
| Vincristine+PDS | 치료 속도 빠름, 치료 기간 단축 - 심각한 ITP에서 0.02mg/kg IV로 병용, 단일용량 단회투약 |
| hIVIG+PDS | PDS 단독보다 좋음 / 너무 비쌈. - Vincristine 병용과 비교했을 때, 둘 다 platelet 회복 시간은 비슷. - 조금 더 싼 vincristine을 선호. |
- Platelet count가 정상 범위로 들어오면, 재발 위험을 고려하여 천천히 tapering.
- 3-6개월 동안은 20-30%/month 이상 빠르게 감량하지 말 것.
- low EOD까지 감량하고, control 잘 되면 아예 끊는 것도 시도해볼 수 있다.
- 치료반응 너무 없으면 골수 검사가 필요하다.
2) 추가 면역억제제
- Steroid만 투여했는데 치료 반응이 떨어질 때, 부작용이 심해 PDS 용량을 줄여야 하는데 그럴 수 없을 때.
- Azathioprine, mycophenolate > cyclosporine 이용
- Cyclosporine이 더 비싸서.. PDS+MMF가 더 선호됨.
- 두 번째 면역 억제제로 잘 치료가 되면 스테로이드부터 감량 > 스테로이드 단약 후 면역 억제제 감량을 천천히 시도
- 만약 재발이 나타나면, PDS (+ 다른 면역억제제) 를 평생 먹어야 할 수도 있다. (최소 혈소판 100,000개는 유지되도록)
- 혈소판 수치 확인 : 약물 용량 변경 전이나, 변경 2주 뒤 꼭 확인.
- Splenectomy : 약물로 잘 치료되지 않고 만성적으로 재발할 때 고려해볼 수 있다,.
3) Supportive care
혈소판이 부족해 지혈이 안 되는 병이니 - 출혈, 상처 최소화가 중요.
- 상처를 방지하기 위해 케이지에서 잘 쉬게 하고, 운동을 제한한다.
- 혈관을 찌르는 venipuncture를 최소화한다. (불안하다고 막 채혈하지 X)
- 꼭 필요한 검사만 한다. (ex-요카테터 장착만으로 감염 일으킬 수 있음, 요검사 등 꼭 필요한 거 아니면 조심.)
- 적절한 수준의 모니터링과 최소한의 채혈 사이에서 균형을 잘 맞춰야.
- New hemorrhage는 없는지 주의 깊게 monitoring 해야 한다.
- Neurologic or ophthalmologic bleeding 등 - 입원 전 없었던 혈뇨 증상이 입원하면서 생겼거나, 눈이나 뇌혈관의 출혈이 생기거나.
- 수의사는 멍이나 혈뇨 등을 대수롭지 않게 여길 수 있지만, 보호자 입장에서는 이해하기 어려움. 사전에 상황을 고지하고 잘 설명해주는 것이 신뢰에 있어 중요하다.
Blood transfusion
- Platelet-rich plasma, platelet concentrate : 이상적이나, 현실적으로 어렵다. 가공 중에 파괴되기도 함.
- Fresh whole blood : 보통 현실적으로 전혈을 많이 준다. (오히려 혈소판 더 많이 들어 있을 수도? / 채혈하고 4℃에서 12h 안에 분리)
- 효과가 48시간을 채 못 가기 때문에, 잠시 증상을 개선하는 용도 외에는 .. ?
- 따라서 RBC는 충분한데 혈소판만 적은 경우에는 권장되지 않는다. (ex. ITP 극초기)
Gastric protectants (위장관보호제)
- Steroid 또는 다른 약물 투여 후 나타날 수 있는 소화기 부작용(GI damage) 방지,
- 혹은 질병 자체적으로 나타나는 위장관 출혈 치료.
- H2 blocker (famotidine) / protone pump inhibitors (omeprazole) / 위산 억제제 (sucralfate)
- Desmopressin : vasopressin 대체 용도로 지혈 기능을 돕기 위해 사용되었으나, 현재는 거의 쓰지 않음.
Evans syndrome (IMHA+ITP) : 항체에 의해 RBC도 파괴, Platelet도 파괴
- 원발인지 속발인지 확인 필요
- 예후가 불량한 편이라 공격적인 치료가 요구됨.
- 치료 guide
-
- Glucocorticoids + adjunctive immunosuppressive
-
- 심각한 경우 (platelet<15,000/μL) Vincristine 1회 처방
-
- Trasfusion : RBC&혈소판 둘 다 파괴 → 전혈(fresh whole blood) 수혈이 좀 더 용이함.
-
- Heparin 치료 금지⛔ : IMHA에서 혈전색전증 방지로 사용되나, 항응고제 처방은 active한 출혈이 있을 때 더욱 조심; 혈소판 감소 상황에서 심한 출혈을 유발할 수 있음.
-
Fig. 치료 프로토콜

Prognosis
- 아주 나쁜 편은 아님, 보통. (Good to guarded)
- 단기 생존률은 좋은 편이나, 짧게 살아남는 경우가 많다. (short-term survival 74-93%)
- 약물 치료에 반응이 좋으나, 재발률이 높은 편 (9-58%)
- 약물 용량 줄이는 과정에서 재발하는 것도 흔하다.
- 병발 시 예후 더 안 좋음.
- Megakaryocytic hypoplasia와 병발할 때
- IMHA 와 병발할 때 (Evans syndrome) : IMHA 단독보다 예후 안 좋다는 근거는 부족.
---5.-Platelets-(Ch.4)/../../../../Settings/Attached-files/Pasted-image-20241126091721.png)



